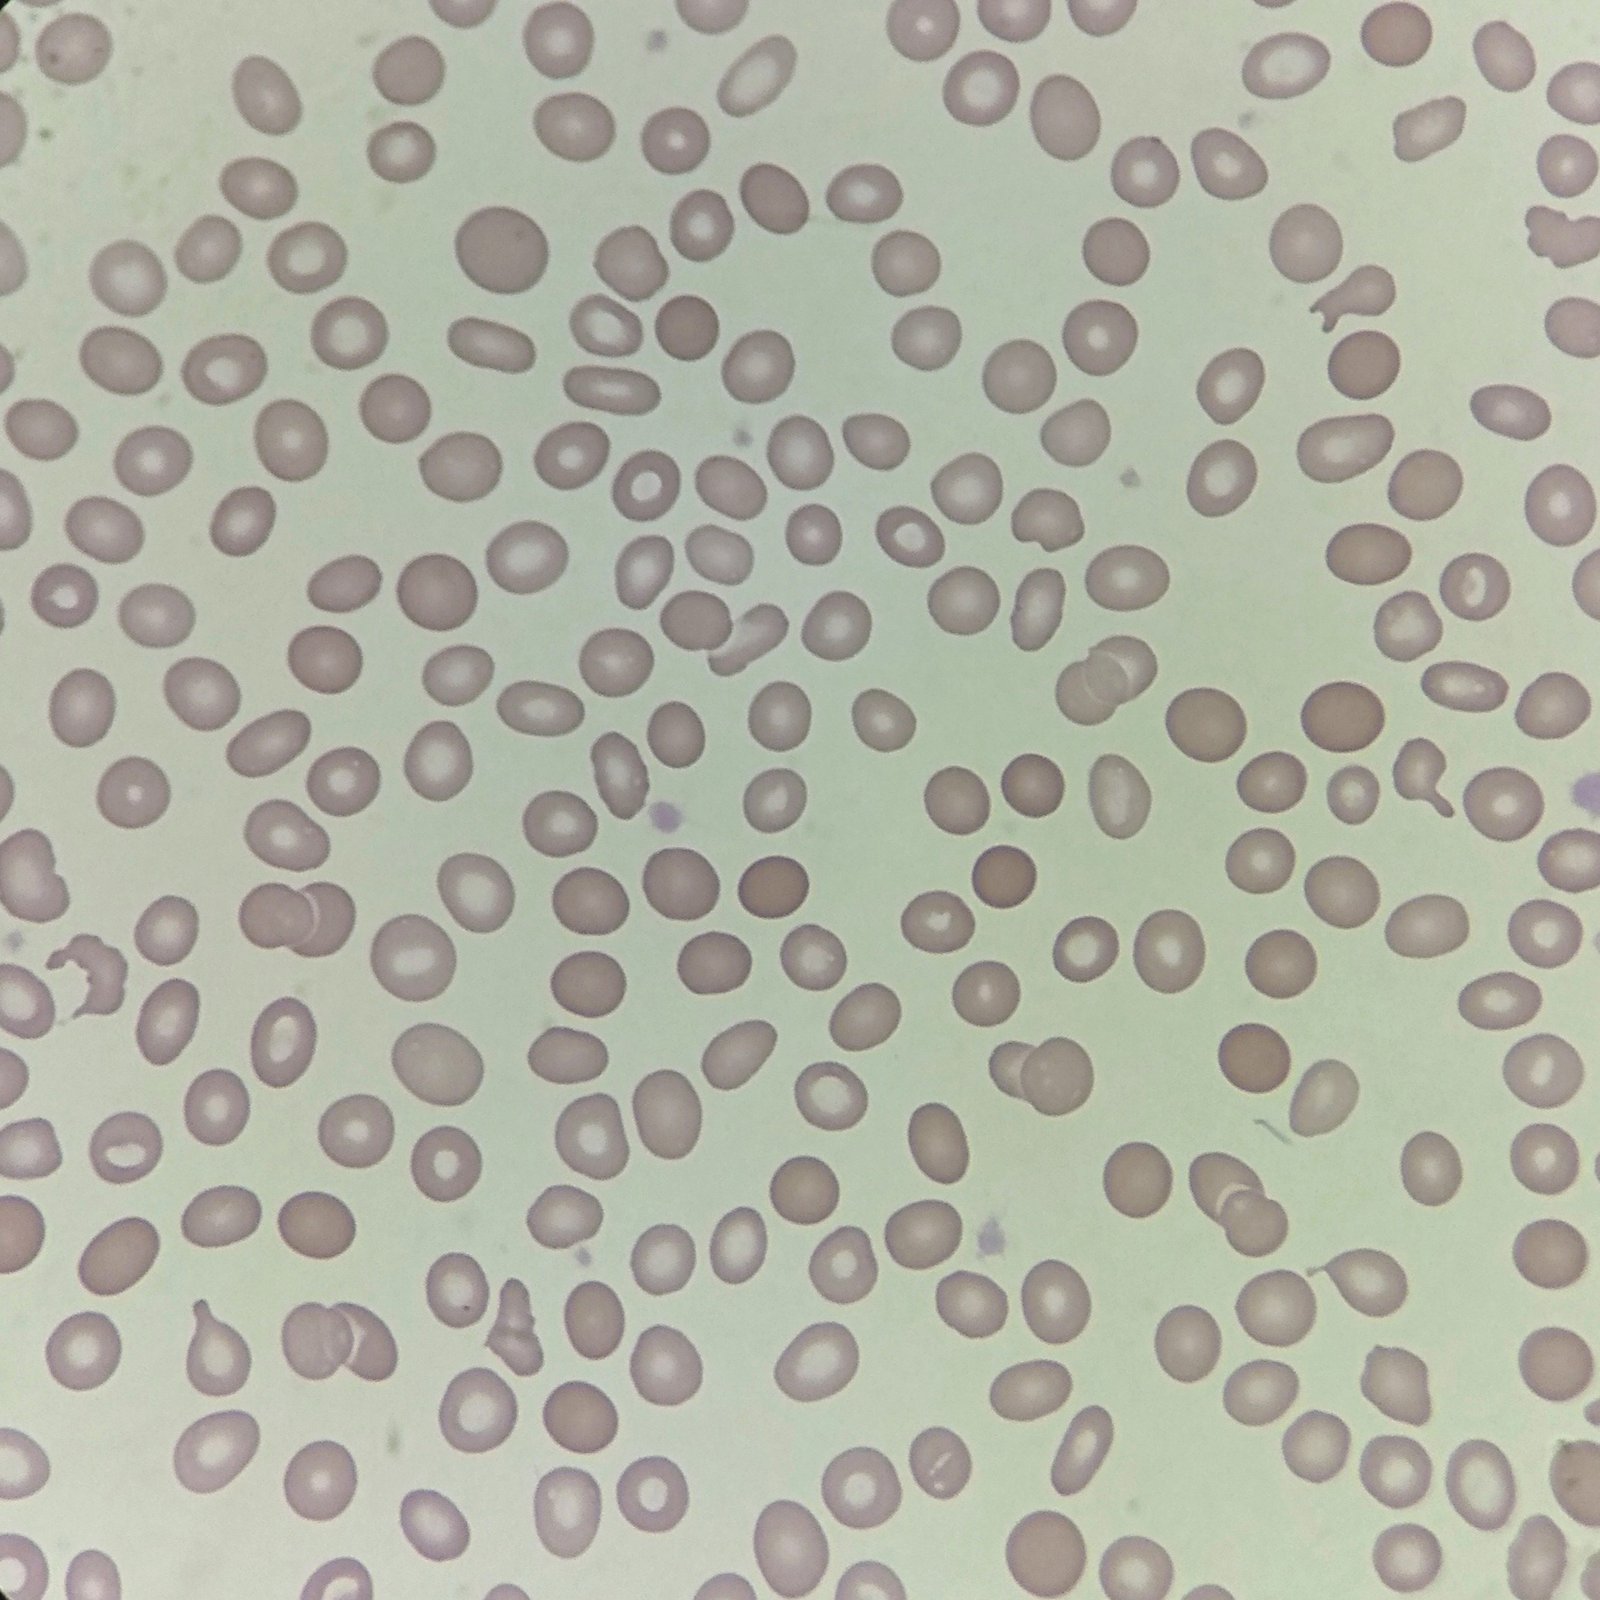
Spherocytes, red blood cell morphology
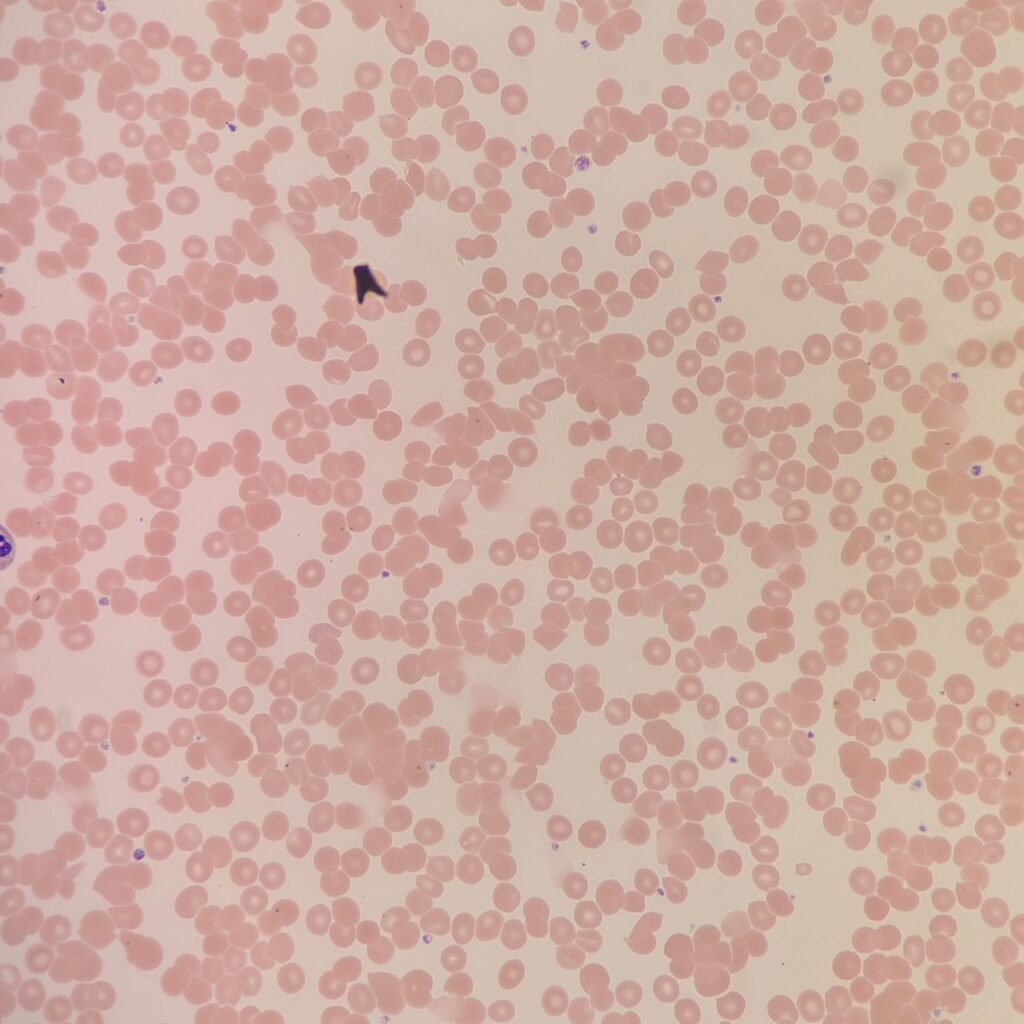
Red blood cells on a slide agglutinating/clumping together from a cold agglutinin.

Acanthocytes
Small, densely-staining cells with several irregular projections.

Blister & Bite Cells
Blister: Cell has vacuole on one side. Caused by removal of inclusions.
Bite: Cell is indented, like someone has taken a bite out of it. Caused by removal of inclusions or bursting of blister cell.
Seen in G-6-PD deficiency and hemoglobinopathies.

Burr Cells
Cell has evenly distributed “bumps” along surface. Central pallor is still visible.
Can be artifactual due to slide preparation. Suspect when found in large numbers or only in certain areas of the slide.

Elliptocytes / Ovalocytes
Ovalocytes are typically more egg shaped while elliptocytes are skinnier and more pencil shaped. Terms are often used interchangeably.

Poikilocytosis
Variation in cell shape.
Coming Soon 😀
Sickle Cells
Thin, crescent-shaped cell with pointed ends, usually lacking central pallor.
Seen in patients with Hgb S (sickle cell)

Spherocytes
Small, spherical RBCs that stain densely and lack central pallor.
May appear as artifact in thinner area of the slide where RBCs have cobblestone effect.
Target Cells
Cell looks like target or bullseye. Ring around central area of hemoglobin should be fairly clear. If it looks “blurry,” the target cell may be artifactual due to slow slide drying or excess EDTA.

Teardrop Cells
Teardrop or pear-shaped cell. Tail should be blunt; Sharp projections all going in the same direction are artifactual from slide-making.

Schistocytes
Fragmented cells with several different subcategories such as helmet cells (AKA bite cells). Cell lacks central pallor.

Stomatocytes
Cell has central slit, making it look like a mouth. If slits are all oriented in the same direction, it is likely artifactual from slow slide drying.

Polychromasia
RBC stains diffusely blue/gray due to residual RNA.
Slightly larger than mature RBC.

Rouleaux
RBCs stack together like coins in a linear fashion. Can be seen normally in thicker areas of the slide.
Excess proteins in blood may also cause the slide to stain more blue.